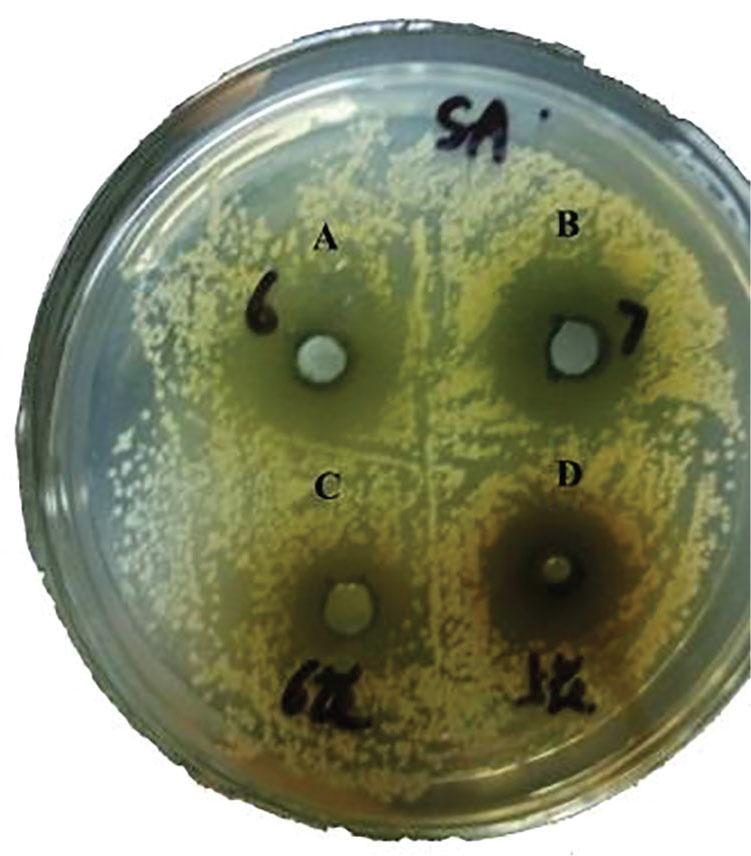
The antibacterial effect on Staphylococcus aureus. (A) Leaves (LE) were collected in June, (B) LE were collected in July, (C) green buds (GB), and (D) flowers (FL). The FL and GB were collected in June 2015.

Figure 1

Figure 2

Figure 3
The contents of nine components in L_ japonica Thunb leaves (LE), green buds (GB), and flowers (FL)
| Compound | Content/mg/g | ||
|---|---|---|---|
| LE* | GB | FL | |
| Galuteolin | 1.80 | 0.03 | 0.045 |
| Neochlorogenic acid | 0.55 | 0.51 | 0.40 |
| Chlorogenic acid | 17.75 | 24.91 | 16.96 |
| Isochlorogenic acid C | 140.47 | 112.20 | 120.09 |
| Caffeic acid | 0.011 | 0.03 | 0.018 |
| Rutin | 13.82 | 0.95 | 2.50 |
| Hyperoside | – | – | – |
| Luteolin | 0.17 | 0.066 | 0.074 |
| Quercetin | – | – | – |
Total flavonoids in L_ japonica Thunb leaves (LE), green buds (GB), and flowers (FL) (n = 3)
| LE* | GB | FL | |
|---|---|---|---|
| Content/% | 6.68 | 7.38 | 6.35 |
| RSD % | 0.63 | 0.41 | 1.42 |
Bacteriostatic results of L_ japonica Thunb leaves (LE), green buds (GB), and flowers (FL)
| Samples | Concentration (g/mL) | Diameters of the inhibition zone (mm) | |||||
|---|---|---|---|---|---|---|---|
| SA | RSD/% | ESBL-SA | RSD/% | EC | ESBL-EC | ||
| LE* | 1.0 | 13 | 0.78 | 14 | 0.74 | – | – |
| GB | 1.0 | 11 | 1.17 | 13 | 0.43 | – | – |
| FL | 1.0 | 12 | 0.45 | 11 | 1.30 | – | – |
Volatile components in L_ japonica Thunb leaves (LE), green buds (GB), and flowers (FL)
| Compound | Content/%* | |||
|---|---|---|---|---|
| LE† | GB | FL | ||
| 1 | 1,4-Eicosadiene1 | 0.94 | 0.47 | 0.42 |
| 2 | Tricosane | – | 0.50 | 0.50 |
| 3 | (Z)-9-Octadecenamide | – | 0.37 | – |
| 4 | 3-Ethyl-5-(2-ethylbutyl)-octadecane | – | 1.42 | – |
| 5 | Heptacosane | – | 6.70 | 7.59 |
| 6 | Tetratriacontane | 6.79 | 4.79 | – |
| 7 | Nonacosane | 10.11 | 30.71 | 32.82 |
| 8 | Tetratetracontane | – | 0.62 | – |
| 9 | Triacontane | 8.33 | 14.60 | 19.67 |
| 10 | 17-Pentatriacontene | 17.67 | 7.24 | 7.24 |
| 11 | Squalene | 8.72 | 0.52 | 0.66 |
| 12 | Pentacosane | – | – | 1.85 |
| 13 | Hexadecanamide | – | – | – |
| 14 | 9-Octadecene,1,1-[1,2-ethanediylbis(oxy)] bis-(Z,Z)- | – | – | – |
| Hydrocarbons/% | 66.07 | 67.94 | 70.75 | |
| 15 | 2-Heptadecanone | – | 1.49 | 1.59 |
| 16 | Bacteriochlorophyll-c-stearyl | 0.41 | – | – |
| 17 | 6,10,14-Trimethyl-2-pentadecanone | 0.17 | – | – |
| 18 | 2-Nonadecanone | – | 0.33 | – |
| 19 | Phytol | 1.85 | 1.90 | 0.52 |
| 20 | (Z)-Ethanol, 2-(9-octadecenyloxy)- | – | 0.20 | – |
| 21 | γ-Sitosterol | 6.92 | 6.58 | 8.35 |
| 22 | (Z,Z,Z)-9,12,15-Octadecatrien-1-ol | – | – | – |
| 23 | Stigmasterol | – | – | – |
| 24 | Trans-Geranylgeraniol | – | – | 0.37 |
| 25 | 14,16-Hentriacontanedione | – | – | 6.74 |
| Alcohol ketones/% | 9.35 | 10.50 | 17.57 | |
| 26 | n-Hexadecanoic acid | – | 0.75 | 3.76 |
| 27 | Phytol, acetate | 3.56 | 1.36 | 1.13 |
| 28 | (Z,Z,Z)-9,12,15-Octadecatrienoic acid | 0.74 | 0.29 | – |
| 29 | (Z)-13-Docosenamide | 6.34 | – | 1.41 |
| Acids/% | 10.64 | 2.40 | 4.89 | |
| 30 | 15-Isobutyl-(13αH)-isocopalane | 1.46 | – | – |
| 31 | 8,14-Seco-3,19-epoxyandrostane-8,14-di-one, 17-acetoxy-3β-methoxy-4,4-dimethyl- | 0.39 | – | – |
| 32 | (3β,24Z)-Stigmasta-5,24(28)-dien-3-ol | – | – | – |
| 33 | (3β)-9,19-Cyclolanost-24-en-3-ol | 13.51 | 10.69 | – |
| Terpenes/% | 15.36 | 10.69 | 0 | |
| 34 | Docosanoic acid, methyl ester | – | 0.41 | – |
| 35 | (Z,Z,Z)-9,12,15-Octadecatrienoic acid, methyl ester | – | – | – |
| 36 | Tetracosanoic acid, methyl ester | – | 3.81 | 1.72 |
| 37 | Hexacosanoic acid, methyl ester | – | 1.26 | 0.72 |
| 38 | Hexadecanoic acid, methyl ester | 0.41 | – | 0.79 |
| 39 | Heptanoic acid, docosyl ester | – | – | – |
| 40 | (Z,Z)-9-Hexadecenoic acid, 9-octadecenyl ester | – | 0.24 | – |
| 41 | Oleic acid, 3-(octadecyloxy)propyl ester | – | – | – |
| 42 | Oleic acid, eicosyl ester | 0.37 | – | – |
| Lipids% | 0.78 | 5.72 | 3.23 | |
| 43 | 2,2-Methylenebis[6-(1,1-dimethylethyl)-4-methyl-phenol] | 1.42 | – | – |
| 44 | Vitamin E | 2.42 | 2.03 | 1.51 |
| Derivatives/% | 3.84 | 2.03 | 1.51 | |